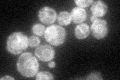
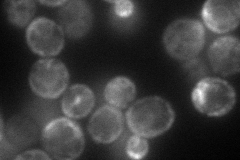
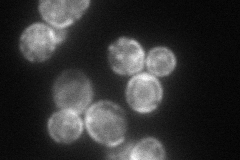
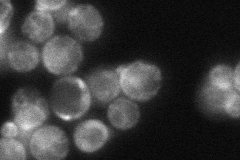
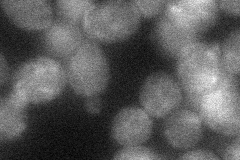
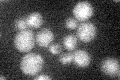
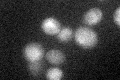

View description
Protein required for the synthesis of wybutosine, a modified guanosine found at the 3'-position adjacent to the anticodon of phenylalanine tRNA which supports reading frame maintenance by stabilizing codon-anticodon interactions
Localization:
Intensity:
Fold change:
Significance:
-
C’ GFP library in SD
ER47.48 -
N' NOP1pr-GFP in SD
cell periphery,ER90.0117 -
N' TEF2pr-mCherry in SD
ER86.469 -
N' NATIVEpr-GFP in SD
ER,bud neck57.2632 -
N' TEF2pr-VC and Cyto-VN in SD
below threshold29.8649 -
C’ GFP library in SD+DTT

ER34.920.73No -
C’ GFP library in SD+H2O2

ER53.111.11No -
C’ GFP library in Starvation Media
ER23.070.48Yes -
C’ GFP library on the background of Pup2-DaMP
vacuole -
C’ GFP library on the background of CCT mutant

ER55.1081.16026No
